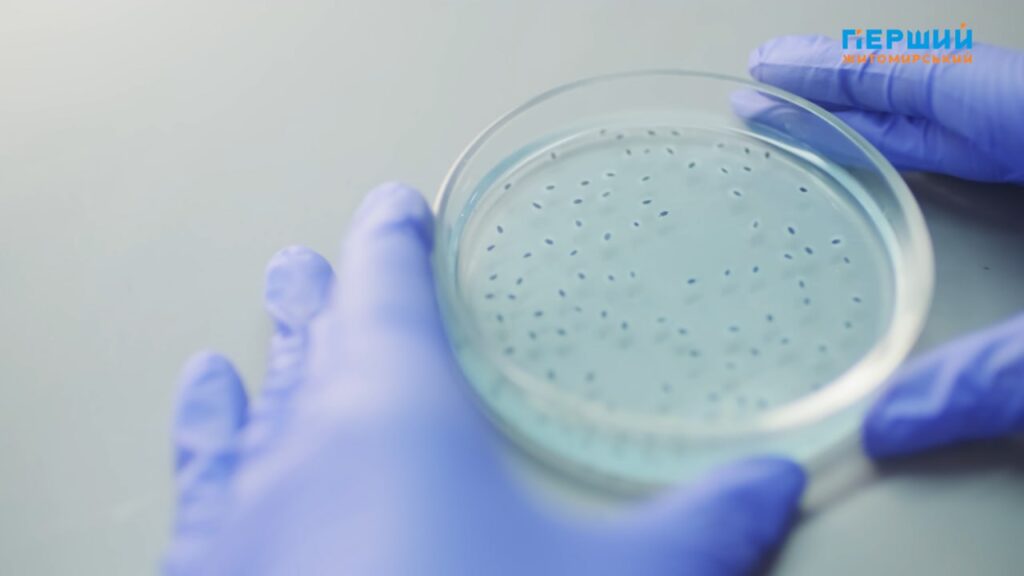

В Україні обов’язковими є щеплення проти 10 небезпечних хвороб: туберкульозу, гепатиту В, кашлюку, дифтерії, правця, поліомієліту, гемофільної інфекції, кору, краснухи, епідемічного паротиту («свинки»). Усі вони внесені до Національного календаря профілактичних щеплень, і держава надає їх безоплатно. Зокрема, вакцина від кашлюку є комбінованою у зв’язці з дифтерією та правцем, і вона є обов’язковою для проведення вагітним жінкам.
Однак є ще кілька інфекцій, щеплення від яких є рекомендованими згідно з розділом 3 наказу МОЗ України №595 від 16.09.2011, та робляться вони за власний кошт.
Про важливість проведення таких вакцин та їхню користь для здоров’я людини Перший Житомирський поговорив з лікарем-педіатром амбулаторії №8 м. Житомира Андрієм Степановим.

Детальніше дивіться у нашому відеоматеріалі.